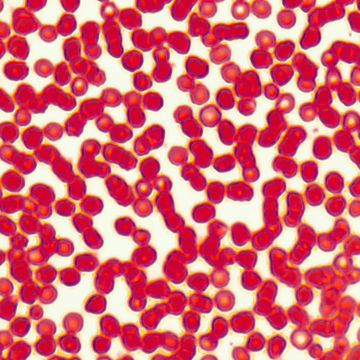
Visa information för Histologi - Crikulationssystemet Bild på Histologi - Crikulationssystemet

Cookies hjälper oss att tillhandahålla våra tjänster och göra ditt besök på vår hemsida till en bättre upplevelse. Genom att använda våra tjänster accepterar du att vi behöver använda cookies.
Mikroskopiska preparat
Preparatsats - Livet i sötvatten
5661
Satsen består av 15 mikroskopiska preparat.
Från 165,00 kr exkl moms
Preparatsats - Universal
5664
En stor preparatsats med hela 100 mikroskopiska preparat till ett fantastiskt pris.
Från 725,00 kr exkl moms
Preparatsats - Biologi
5677
en sats med 25 olika preparat lämpliga för undervisning inom biologi.
Från 288,00 kr exkl moms
- 1
- 2